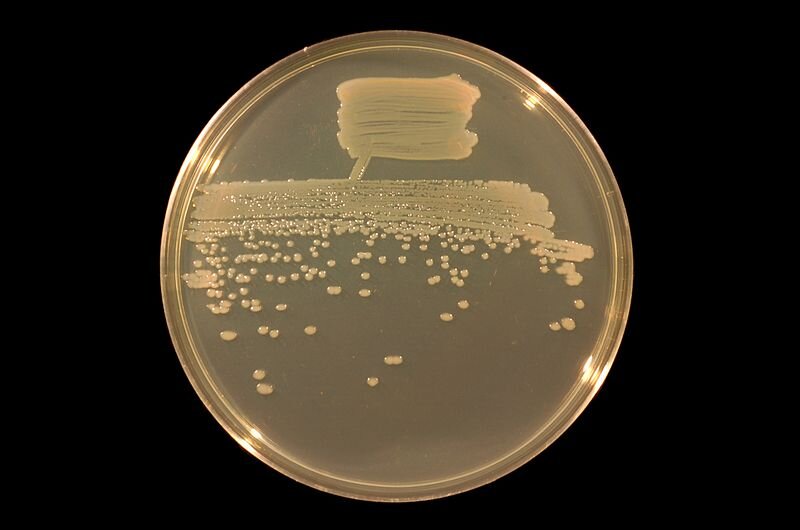
Zdjęcie przedstawia szalkę Petriego, na której wyhodowano mikroorganizmy. Szalka pokryta jest rozmazami oraz kulistymi formami.

Przeczytaj
Na ratunek glebie i wodzie
Intensywne uprzemysłowienie wymaga surowców i paliw (energii). Są one wydobywane z ziemi, co wiąże się także ze zniszczeniem różnorodności biologicznej na tym terenie (np. kopalnia odkrywkowakopalnia odkrywkowa), zanieczyszczeniami (np. wskutek awarii szybu naftowego) czy pozbawieniem naturalnych funkcji (np. zajęcie terenu pod magazyn). DegradacjaDegradacja środowiska to współcześnie coraz ważniejszy problem.
Ekologia restytucyjnarestytucyjna zajmuje się inicjowaniem i przywracaniem zdolności odbudowy ekosystemu, który może być zdegradowany (utracił wiele ze swoich funkcji), zaburzony (przejawia tylko niektóre funkcje) lub zniszczony (nie może funkcjonować). Świadomość, że gleba jest jednym z głównych składowych ekosystemu sprawia, iż największy nacisk kładzie się na odbudowę jej utraconych funkcji. Wykorzystuje się do tego głównie dwie strategie: bioremediację i bioaugmentację.

Na zdjęciu: wyciek oleju na jeziorze Maracaibo.
Bioremediacja a bioaugmentacja
Wspomaganie z użyciem bakterii i grzybów
Bioaugmentacja nie jest nową metodą. Już w ubiegłym wieku na zdegradowanych terenach sadzono rośliny, np. łubin, lucernę czy grykę, które żyją w symbiozie z bakteriami brodawkowymi. Bakterie te wzbogacają glebę w azot. Dzięki dostępności związków azotowych łatwiej mogły się rozwijać inne rośliny, a do gleby trafiało więcej szczątków organicznych – tworzyła się warstwa próchnicy.
Tam, gdzie warstwę próchnicy zniszczono, można wspomagać rośliny, dodając do gleby tzw. szczepionki mikoryzowemikoryzowe. Wiele roślin tworzy symbiotyczny związek z różnymi gatunkami grzybów, dzięki czemu są odporne i lepiej się rozwijają – grzybnia otrzymuje od rośliny związki organiczne, a dostarcza im wodę z solami mineralnymi. Ponadto rozrastająca się sieć strzępek, czyli elementów grzybni, wnika między cząsteczki gleby, poprawiając jej strukturę. Aby ułatwić roślinie znalezienie jej grzybowego partnera wykorzystuje się specjalne preparaty o składzie dostosowanym do potrzeb konkretnych upraw, np. traw, drzew czy storczyków. Raz zaaplikowany preparat wspomaga roślinę przez całe jej życie. Grzyby mikoryzowe wchłaniają wiele metali ciężkich, np. kadm czy ołów, ograniczając ich pobieranie przez rośliny.

Rola biotechnologii we wspomaganiu ekologicznym
Różne bakterie prowadzą metabolizm w warunkach tlenowych lub beztlenowych, jak np. szczepyszczepy rozkładające węglowodory, takie jak benzen czy toluen. Inne mikroorganizmy rozkładają ścieki komunalne i przemysłowe. Są one wyszukiwane oraz izolowane z pomocą metod biologii molekularnejbiologii molekularnej. Następnie trzeba je dobrze poznać i zrozumieć ich rolę: analizuje się ich właściwości, zachowanie, zależności i funkcje w ekosystemie, rozmnażanie. Bakterie używane do bioaugmentacji są sprawdzane i namnażanenamnażane w laboratorium i ponownie wprowadzane do środowiska. Możliwe jest też uzyskanie szczepów bakteryjnych modyfikowanych genetycznie, wykazujących pożądane cechy, np. szybszy wzrost, lepsze rozkładanie toksyn niż szczepy występujące w środowisku. Wiąże się to jednak z ryzykiem ich niekontrolowanego rozprzestrzenienia i nieprzewidywalnymi zmianami w ekosystemach.

Słownik
nauka badająca, w jaki sposób funkcjonowanie organizmów zależy od właściwości budujących je cząsteczek
proces niszczenia środowiska i jego zasobów; ubożenie składu gatunkowego, zmniejszenie biologicznej aktywności gatunków, pogorszenie jakości środowiska
kopalnia, w której prace wydobywcze są prowadzone na powierzchni ziemi i polegają na odkrywaniu kolejnych warstw surowców, np. węgla brunatnego, piasku, żwiru
(gr. mykes, - grzyb; rhiza – korzeń); powszechne zjawisko współżycia grzybów z korzeniami roślin wyższych; występuje u ok. 85 proc. gatunków roślin na świecie
strzępki grzyba wnikają do tkanek rośliny
strzępki grzyba oplatają korzenie roślin tworząc opilśń
proces powielania, zwiększania ilości, np. wirusów w komórkach gospodarza
(łac. re- - ponownie; natura – przyroda, istnienie); przywrócenie zmienionemu środowisku stanu możliwie najbliższego pierwotnemu, np. naturalnego koryta rzeki po jej regulacji
(łac. restituo,- naprawa, odtwarzanie, przywracanie); przywrócenie wymierającego gatunku lub stanu środowiska, zaburzonego wskutek działalności człowieka
czysta hodowla lub próbka bakterii pochodzących od jednej komórki, a więc identycznych genetycznie